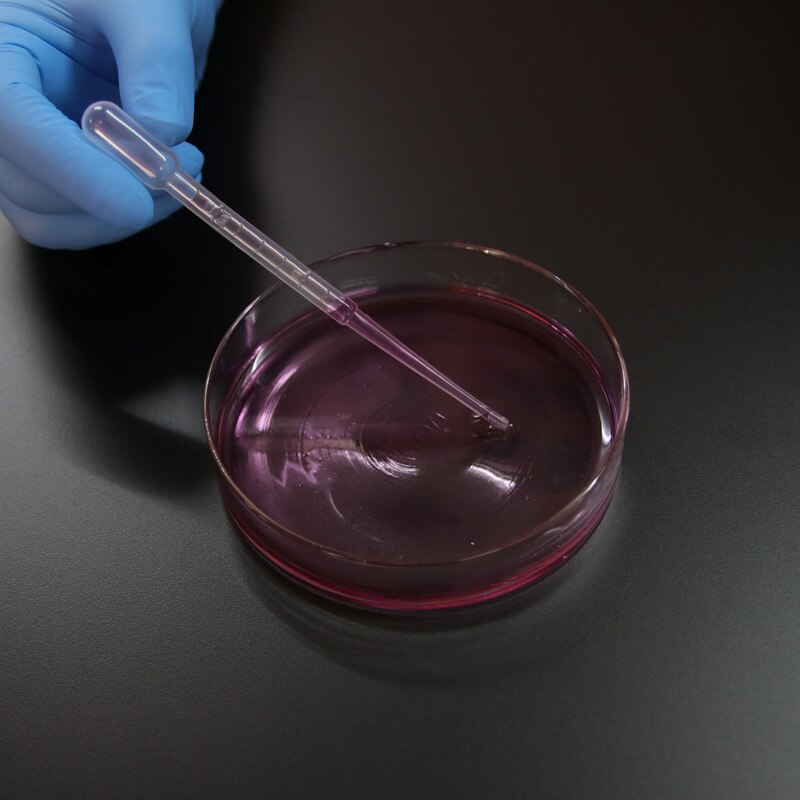
20 Pieces Laboratory Plastic sterile 15mm * 60mm Petri Dish

- Free shipping
- 100 days returns
- Low prices
- 5 million products
20 Pieces Laboratory Plastic sterile 15mm * 60mm Petri Dish
Specifications:
- Origin: CN(Origin)
- Capacity: 60mm
- Size: 60mm
- Product Name: 60mm Petri dish
- Model Number: V1
- Classification: Petri Dish

- Free shipping
- 100 days returns
- Low prices
- 5 million products